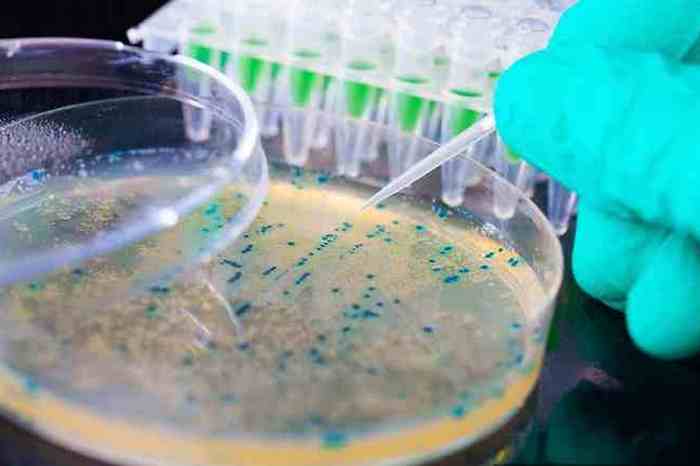

Бессмертие как реальность.
В научной фантастике и поп-культуре бессмертие является одной из самых популярных тем. А в реальности бессмертными становились разве что великие люди, имена которых оставались в истории на века. Но люди продолжают мечтать о физическом бессмертии. Тем более, что сегодня появилась масса научных предпосылок, которые позволяют верить, что нет ничего невозможного человеческое бессмертие реально.
1. Исследования теломеразы

Шаг в обретение бессмертия: исследования теломеразы.
Это просто человеческая природа: с течением времени человеческое тело медленно ухудшается. Кожа теряет эластичность, становится морщинистой, кости становятся слабыми и хрупкими – этот список можно продолжать. Естественно, поскольку это происходило со всеми людьми на протяжении веков, все считают это само собой разумеющимся.
Но это вовсе не означает, что всегда будет так. На окончании хромосом у людей находится теломераза — фермент, который используется, чтобы сохранить их в безопасности и предотвратить распутывание. Когда люди молодые, то теломераза работает прекрасно, однако, с течением времени клетки копируются и расширяются, а теломераза изнашивается и повреждается.
Чем больше теломераза изнашивается, тем быстрее становится процесс старения. Если бы «обуздать» этот конкретный фермент, то люди могли бы быть вечно молодыми. Сейчас проводятся опыты на мышах по замене теломеразы на другой фермент.
2. Загрузка памяти

Шаг в обретение бессмертия: загрузка памяти.
Загрузка памяти, сканирование мозга или эмуляция всего мозга – можно называть это как угодно, но эта классическая тема из научной фантастики в скором времени станет реальностью. Один из основных игроков в данном направлении – «Россия 2045». Эта российская некоммерческая организация, основанная в 2011 году, объединяет специалистов по нейронному интерфейсу, робототехнике, искусственным органам и т.д., которые хотят сделать загрузку личности реальной.
В частности, их «Проект Аватар» предназначен для того, чтобы внедрить мозг человека в роботизированное тело. Однако, не все так гладко. В частности, один из основных вопросов заключается в том, что объем информации человеческого мозга намного больше, чем позволяет хранить обычный компьютер.
3. Нанотехнологии

Шаг в обретение бессмертия: нанотехнологии.
Стоит только представить себе — маленькие крошечные машины внутри человеческого тела, которые плавают в потоке крови или даже заменяют ее. Всякий раз, когда тело повреждается, они залечивают рану. Если тело теряет конечность, то отрастает новая на замену.
Удар молнии теперь будет не страшен, да и выпав из окна, можно будет выжить. Этот метод уже работает. Исследователи из Массачусетского технологического института уже использовали наночастицы для разрушения опухолей яичников у мышей и для выявления сгустков крови в образцах человеческой мочи.
4. Клонирование частей тела

Шаг в обретение бессмертия: клонирование частей тела.
Это помогло бы множеству людей, которые ждут очереди на трансплантацию органа. Не было бы таких гигантских списков очередников. Также это помогло бы с безопасным тестированием косметических и медицинских продуктов, поскольку позволило бы тесты без риска нанесения возможного вреда людям или животным.
Хотя полностью человеческое существо пока еще не клонировали, уже были созданы искусственно различные «запчасти» людей (например, взрослые стволовые клетки были клонированы из человеческой кожи). Ученые надеются, что они смогут использовать эти стволовые клетки для регенерации тканей у пожилых людей.
5. Выращенные лабораторным способом органы
Шаг в обретение бессмертия: выращенные лабораторным способом органы.
Подобно клонированию, выращенные в лаборатории органы помогут спасти жизни людей путем предоставления какой-либо части тела тем, кто в ней нуждается. Очереди на пересадку очень длинные и многие люди умирают, прежде чем они могут получить то, что им нужно. Подобно клонированию, выращенная часть тела будет содержать ДНК человека, которому необходима пересадка, но этот процесс немного отличается.
3D принтеры уже используются для создания органических частей тела для людей, которые нуждаются в них. С помощью биопсии собирают клетки у донора, после чего смешивают их со специальной жидкостью, полной питательных веществ, чтобы сохранить их живыми. Затем из этих клеток 3D принтер формирует часть тела. Опять же, как и в случае с клонированием, есть ограничения. Сейчас можно выращивать только простые органы: кожу, печень и мочевой пузырь, но идут дальнейшие исследования этой технологии.
6. Кибернетика

Шаг в обретение бессмертия: кибернетика.
Подобно 3D-печати частей тела, на подъеме находятся механические «запчасти» для людей. По большей части, они используются в медицинских целях, например в виде протезов рук или ног. Также люди могут просто решить обновить свои части тела по эстетическим причинам.
Уже есть довольно большая субкультура людей, которые решили изменить себя по последней причине. Биохакинг существует уже в течение около 20 лет – люди изменяют себя имплантатами, которые светятся под кожей или изменяют форму рук. Крупные корпорации, такие как Google, сейчас ведут исследования в том, как биохакинг может улучшить общее состояние здоровья человека.
7. Крионика

Шаг в обретение бессмертия: крионика.
Криогенная инженерия уже разрабатывается в течение достаточно долгого времени. А смыслом этого всего является заморозка человеческого разума и тела и сохранение его до тех пор, пока момента времени, когда пожелает человек перед заморозкой или до тех пор, пока не найдут способ лечить неизлечимую ныне болезнь, которой болеет этот человек.
Криогенная заморозка подразумевает снижение температуры тела до такого уровня, что организм впадает в спячку, а все его функции замедляются. Функция мозга становится настолько незначительной, что организм не нуждается в большом количестве кислорода, а обмен веществ происходит очень медленно. Это похоже на спячку медведя.
8. Виртуальная реальность

Шаг в обретение бессмертия: виртуальная реальность.
После появления фильма «Матрица» идея о жизни в компьютерной симуляции действительно потрясла научный мир. Исследователи полагают, что действительно может быть вероятность того, что мы на самом деле живем в симуляции (причем довольно много ученых считают, что вероятность этого составляет 20-50%).
Равно как и загрузку памяти, виртуальную реальность считают одним из многих способов, с помощью которых люди могли бы достичь вечной жизни с помощью цифровых средств. Ведь сознание человека смогло бы продолжить жить в компьютерной симуляции. При использовании облачных вычислений можно создать огромные миры, в которых жизнь для людей не отличалась бы от реальной.
9. Космические путешествия

Шаг в обретение бессмертия: космические путешествия.
Поскольку старение лишь немного медленнее, в космосе, чем на Земле, многие считают, что для того, чтобы люди стали бессмертными, они должны исследовать Вселенную. Также жизнь на другой планете будет гарантировать, что люди выживут, если Земля подвергнется какому-либо катаклизму.
10. Генная терапия

Шаг к обретению бессмертия: генная терапия.
Всегда, когда смотришь фильм, в котором кого-то подстрелили, но он выжил, думаешь, что это было бы совершенно невозможно в реальной жизни. Однако, благодаря генной терапии, реальность может превзойти кинематографический вымысел. Генная терапия до сих пор просто заменяла отсутствующие или дефектные гены нормальными.
Благодаря технологическим достижениям ученые работают над сплавлением клетки кожи человека с протеинами паучьего шелка. В отличии от бронежилетов, которые замедляют пули, а иногда и останавливают их, этот новый тип кожи будет полностью предотвращать попадание пули внутрь тела человека. Это, в сочетании с генной инженерией, может в значительной степени увеличить продолжительность жизни человека.
И в продолжение темы ещё 15 футуристических технологий, которые могут появиться в ближайшем будущем. И это уже реальность!
Источник: